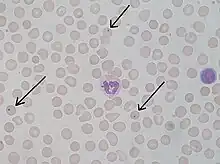

Justin Jolly
Justin Marie Jules Jolly, né à Melun le et mort à Paris le , est un hématologiste et un histologiste français.
Aperçu biographique
Il naît dans une famille de magistrats et de médecins de la Champagne. Son père, Paul Jolly (1840-1908), est magistrat et termine sa carrière comme Doyen des juges d'instruction du Tribunal de la Seine. Il est l'arrière-petit-fils de Paul Jolly, médecin membre de l'Académie de médecine. Parent par sa grand-mère maternelle de Cruveilhier, il s'engage dans la voie médicale après avoir fréquenté le lycée Louis-le-Grand. Il s'attache particulièrement à l'étude de l'anatomie enseignée par Farabeuf.
En 1894, Justin Jolly est reçu interne des hôpitaux. Dès 1895, il est répétiteur à l'École des hautes études et suit les cours d'histologie d'Eugène Suchard (1852-1915)[1], répétiteur au Collège de France. Il sera là le disciple des professeurs Louis Charles Malassez et Louis-Antoine Ranvier. Auprès de ces maîtres, il apprend les techniques histologiques en lien avec différentes disciplines médicales. Il est reçu docteur en médecine en 1898, en soutenant une thèse consacrée aux différentes variétés des leucocytes.
Il est nommé chef du laboratoire à l'Hôtel-Dieu de Paris entre 1899 et 1903, puis directeur du laboratoire d'histologie de l'École pratique des hautes études en 1912. Il est nommé chef de laboratoire à l'Institut du radium en 1919. De 1925 à 1940 il est professeur au Collège de France, à la chaire d'histophysiologie.
Il est l'un des fondateurs de la Revue d’hématologie.
Travaux scientifiques
Très tôt, sous l'influence de Malassez, il se voue à l'étude du sang et de l'hématopoïèse, devenant l'un des pionniers de l'hématologie du début du XXe siècle. Il montre que le globule rouge des mammifères est d'abord une cellule nucléée qui perd son noyau par pycnose. Il observe in vivo la circulation capillaire des hématies des ailes de chauve-souris. Il étudie l'activité et le phénomène de margination des leucocytes, décrit la mobilité des lymphocytes et observe les précurseurs des cellules sanguines : myéloblastes et myélocytes. Il publie des recherches sur la rate, le thymus, les organes lymphoïdes et la formation embryologique des vaisseaux sanguins.
À l'Institut du radium, il étudie avec Antoine Lacassagne les effets de rayons X sur les tissus et notamment sur les leucocytes.
Il produit, avec Commandon et Fonbrune, les premiers films sur la mitose de cellules vivantes par micro-cinématographie. En 1923, il publie un influent manuel en deux volumes contenant plus de sept cents figures : le Traité technique d'hématologie, faisant l'état des connaissances hématologiques de l'époque.
Éponymie
- Avec le physiologiste américain William Henry Howell (1860-1945), il décrit les éléments appelés plus tard corps de Howell-Jolly, qui sont des granules d'un à deux microns observé dans les érythrocytes, résidus nucléaires d'érythroblastes ou de fragment de chromosomes. Ces inclusions intra-értyhrocytaires sont plus fréquemment observées en cas d'asplénisme anatomique ou fonctionnel.
Titres et distinctions
- Professeur au Collège de France.
- Élu membre libre de l'Académie des sciences en 1939.
- Membre () puis président pour 1947 de l'Académie nationale de médecine[2].
- Membre de la Société anatomique de Paris.
- Secrétaire général de la Société de biologie[3].
 Officier de la Légion d'honneur (1939)[4].
Officier de la Légion d'honneur (1939)[4].
Œuvres et publications
- Recherches sur la valeur morphologique et la signification des différents types de globules blancs, [Thèse de médecine, Faculté de médecine de Paris, 1898], 51 p.
- Titres et travaux scientifiques, G. Steinheil (Paris), 1904, Texte intégral.
- « Sur la formation des globules rouges des mammifères », in: Comptes rendus de la Société de Biologie, Paris, 1905.
- Traité technique d'hématologie, A. Maloine (Paris), 1923.
- « L'histophysiologie et les tendances modernes de l'histologie » [Leçon inaugurale au Collège de France, le ], in: Paris médical : la semaine du clinicien, 1926, 59, 19, p. 445-56, Texte intégral.
- « L'induction organisatrice et le problème du cancer », in: La Presse médicale, 1937, p. 1084-85, Texte intégral.
- Le Sang dans la vie de l'organisme, Flammarion, Bibliothèque de philosophie scientifique (Paris), 1946.
Notes et références
Annexes
Articles connexes
Bibliographie
- G. Milian: « Justin Jolly », in: Paris médical : la semaine du clinicien, 1939, n° 114, p. 97-98, Texte intégral.
- A. Chevalier: « [In memoriam Justin Jolly », in: C R Hebd Seances Acad Sci., 1953 Fev 9;236(6):553-7.
- Maurice Loeper: « Mort de M. Justin Jolly », in: Bull Acad Natl Med., 1953 Fev 3-10;137(5-6):74-5.
- C. Laubry: « Justin Jolly (1870-1953) », in: Rev Hematol., 1953;8(2):230-4.
- Robert Courrier: « Funérailles de Justin Jolly à La Chaussée-sur-Marne (Marne) le mercredi », Institut de France, 1953, Texte intégral.
- Robert Courrier: Notice sur la vie et les travaux de Justin Jolly, [Lecture faite en la séance annuelle des prix du ], Institut de France, 1968 - 40 p.
- Anne Madeleine Rollet: La vie et l'œuvre du professeur Justin Jolly [Thèse de médecine, Université de Paris VII, Faculté de médecine Lariboisière-Saint-Louis], 1971.
Liens externes
- Ressources relatives à la recherche :
- Ressource relative à la santé :
- Ressource relative à la vie publique :
- « Justin Jolly - Curriculum vitae pour la nouvelle édition du "Biographisches Lexikon der hervorragenden Ärzte" », Europeana (consulté le )
- Portail de la médecine
- Portail de l’hématologie
- Portail de la France